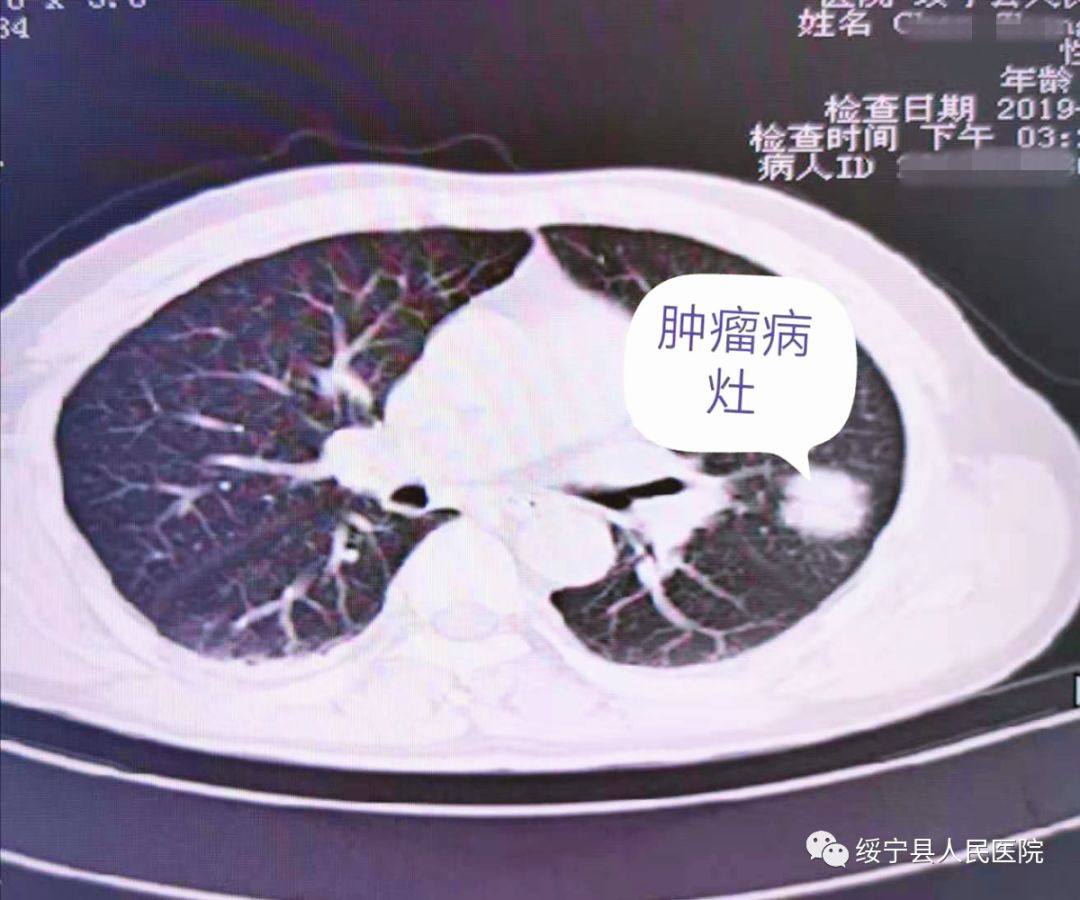

新技术 新突破近日,在湘雅医院胸外科专家高阳教授和麻醉科专家宋宗斌教授的指导下,绥宁县人民医院神经外科联合麻醉手术科完成首例双腔气管插管麻醉下胸腔镜肺癌根治术,此例手术的成功开展,让绥宁老百姓享受到省级医院的诊疗服务,在家门口也能做肺部肿瘤手术。

病史简介

患者陈某某,男性,56岁,因“头胸部外伤后疼痛3小时”入住绥宁县人民医院神经外科,完善胸部CT提示:左上肺占位,倾向于周围型肺癌。

图为胸部CT检查

图为术前湘雅医院宋宗斌教授(左1)、绥宁县人民医院神经外科主任邓泽亮(左2)和麻醉科副主任陆居兵(右2)查看病人
经积极对症治疗,患者外伤病情稳定后,10月13日,高阳教授、宋宗斌教授及绥宁县人民医院神经外科、麻醉科医生的相互配合,在双腔气管插管麻醉下采用胸腔镜行肺癌根治术,术后病理确诊为鳞癌。手术创伤小,术后病人恢复速度快,3天后即可下床活动。

图为手术现场,湘雅医院高阳教授(右1)、宋宗斌教授(左1)、神经外科主任邓泽亮(左2)。
总结:肿瘤并不可怕,贵在早期发现、早期诊断、早期治疗。该患者有长期吸烟史,本次就诊因外伤入院,行胸部CT检查发现肺部肿瘤,为I期肺癌,发现早、治疗早,大大改善预后及生存质量。
知识点普及

肺癌
肺癌是发病率和死亡率增长最快,对人群健康和生命威胁最大的恶性肿瘤之一。与发达国家约达70%的肺癌治愈率相比,目前我国肺癌总治愈率仅为30%,这是由于肺癌早期症状不明显,大家对肺癌早期发现意识不足,肺癌患者发现时已经是中晚期,整体现状不容乐观。肺癌的治疗关键:早期诊断和早期治疗,并最终降低病死率。由于筛查技术的进步,先进国家肺癌确诊时有2/3可手术切除,而我国却有2/3属晚期,已无法手术。国际早期肺癌行动项目和美国全国癌症筛查试验的随机对照研究表明,通过低剂量螺旋CT筛查,临床I期肺癌术后10年的生存率达88%,在诊断后1个月内手术为92%;而同样I期肺癌拒绝手术的8例皆在5年内死亡。如将低剂量螺旋CT筛查与普通X线检查相对照,则前者肺癌检出率是后者的10倍,病死率进一步降低了20.3%。2015年中华医学会放射学分会心胸组发布“低剂量螺旋CT肺癌筛查专家共识”建议中将高危人群定义为:★年龄50-75岁;★至少合并以下一项危险因素:①吸烟大于20包/年,其中包括曾经吸烟,但戒烟时间不足15年者;②被动吸烟者;③有职业暴露史(石棉、铍、铀等接触者);④有恶性肿瘤病史或肺癌家属史;⑤有COPO或弥漫性肺纤维化病史。

双腔气管插管的适应症

★肺脏手术:大咯血、肺结核、肺脓肿、支气管扩张、肺大泡等;
★支气管胸膜瘘、气管食管瘘;
★拟行肺叶或全肺切除术的病人;
★外伤性支气管断裂及气管或支气管成术;
★食管肿瘤切除或食管裂空疝修补;
★胸主动脉瘤切除术等。

双腔气管插管的优点
★肺的隔离,防止患侧肺污染健侧肺。
★可显著改善开胸术野,即开胸侧肺不通气,肺塌陷,术野清楚。
★可以分别吸引、通气。
温馨提示:谈癌无需色变,及早发现肿瘤的蛛丝马迹,让每个人远离癌症,低剂量薄层CT扫描让早期肺癌无处可逃。
专家简介

高 阳
中南大学湘雅医院胸外科专家、副主任医师、副教授、硕士生导师
学术任职:中国医师协会胸外科医师分会手汗症专家组委员、中国研究型医院协会胸外科专业委员会委员、中国抗癌协会肿瘤靶向治疗专业委员会青年委员、中国医疗保健国际交流促进会胸外科分会委员、湖南省医学会胸外科专业委员会委员、湖南省医学会肿瘤学专业委员会委员。
个人专长:专业主攻胸部疾病的微创外科治疗,肺切除手术术后并发症处理,肺GGN病变及亚肺叶切除。
专家简介

宋宗斌
中南大学湘雅医院麻醉科专家、硕士生导师、麻醉学博士
2016年-2017年美国辛辛那提大学医学院麻醉学系博士后培训,主持国家自然科学青年基金及湖南省自然科学基金,以第一作者或通讯作者在《pain》等国际知名期刊发表SCI论文7篇。担任湖南省麻醉医师协会秘书、青年委员,《临床麻醉学杂志》青年编委。
主要从事:心血管手术麻醉及围术期急慢性疼痛机制研究。
稿源:邓泽亮、陈艳成